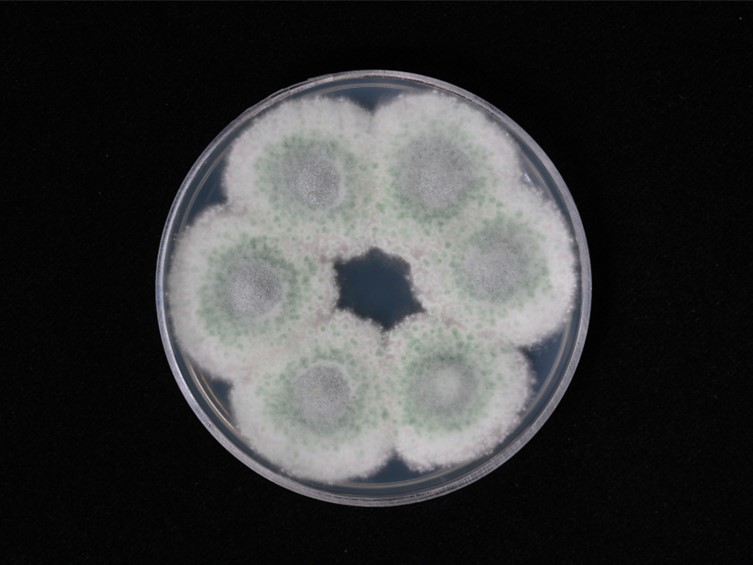

Holotype:
THAILAND, Prachin Buri Province, Khao Yai National Park, 2 Jun. 2011, K. Tasanathai, S. Mongkolsamrit, P. Srikittikulchai, A. Khonsanit, W. Noisripoom, holotype BBH 30607, ex-type living culture BCC 47979.
Habitat:
Buried in the ground.
Host:
Lepidoptera larva.
Description:
 Stromata usually branched, 50-86 × 1-2 mm, broad, stipe cylindrical, somewhat flat, pale yellow to greyish yellow, fertile area cylindrical with pointed ends, white, pale yellow to greyish yellow, 0.8-1.7 × 1 mm. Rhizoids flexuous, up to 7 cm underground.
Stromata usually branched, 50-86 × 1-2 mm, broad, stipe cylindrical, somewhat flat, pale yellow to greyish yellow, fertile area cylindrical with pointed ends, white, pale yellow to greyish yellow, 0.8-1.7 × 1 mm. Rhizoids flexuous, up to 7 cm underground.  Perithecia scattered or crowded, greyish yellow to brown, oblique in arrangement, clavate to ovoid with slightly protruding, bent ostioles, 320-470 × 180-300 μm.
Perithecia scattered or crowded, greyish yellow to brown, oblique in arrangement, clavate to ovoid with slightly protruding, bent ostioles, 320-470 × 180-300 μm.  Asci hyaline, cylindrical, 100-271 × 3-5 μm, apical cap prominent, 1 × 2 μm.
Asci hyaline, cylindrical, 100-271 × 3-5 μm, apical cap prominent, 1 × 2 μm.  Ascospores filiform, hyaline, whole, 94-107 × 1 μm.
Ascospores filiform, hyaline, whole, 94-107 × 1 μm.
Culture characteristics:
Colonies on PDA initially colourless, turning green due to the production of green conidia after 7 d. Vegetative hyphae smooth-walled. Conidiophores erect, resembling Isaria but not having tapering long necks, bearing dense whorls of branches, each bearing 3–5 conidiogenous cells. Phialides ovoid to obpyriform with short distinct neck, 3–5 × 2 μm. Conidia subglobose, green, 3–5 × 1.5–2.5 μm.
Colonies on PDA initially colourless, turning green due to the production of green conidia after 7 d. Vegetative hyphae smooth-walled. Conidiophores erect, resembling Isaria but not having tapering long necks, bearing dense whorls of branches, each bearing 3–5 conidiogenous cells. Phialides ovoid to obpyriform with short distinct neck, 3–5 × 2 μm. Conidia subglobose, green, 3–5 × 1.5–2.5 μm.
Reference:
Mongkolsamrit S, Khonsanit A, Thanakitpipattana D, et al. (2020). Revisiting Metarhizium and the description of new species from Thailand. Studies in Mycology 95: 171–251.
DOI: https://doi.org/10.1016/j.simyco.2020.04.001Species |
Strain |
Compound |
Pubchem CID |
Biological activity |
Reference |
|---|
|
Strain |
ITS | LSU | RPB1 | SSU | TEF1 |
|---|---|---|---|---|---|
| BCC 47950 | KC011176 | KC011180 | KC011184 | KC011172 | KC011186 |
| BCC 47979 | KC011177 | KC011181 | KC011185 | KC011173 | KC011187 |